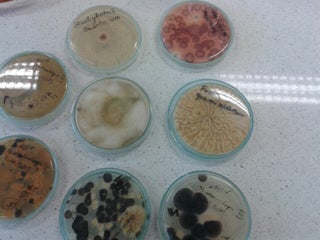

Wydział Biologii i Ochrony Środowiska UŁ budynek D
doesn’t have
any reviews yet.
Hast du diesen Ort besucht?
Öffne unsere App
und schreib deine Meinung.
doesn’t have
any reviews yet.




 Menu
Menu